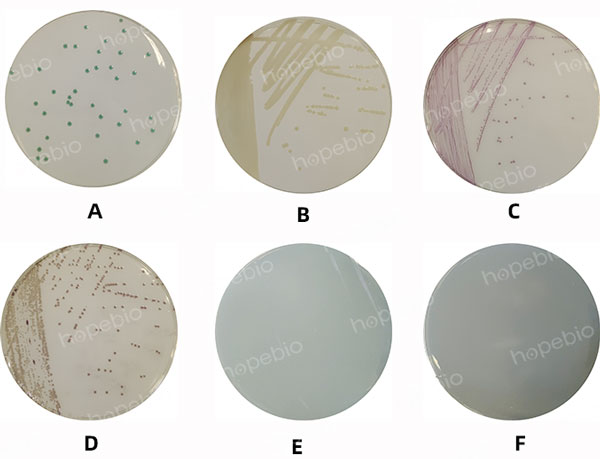

海博微信公众号
海博微信公众号
 海博天猫旗舰店
海博天猫旗舰店


 海博微信公众号
海博微信公众号
 海博天猫旗舰店
海博天猫旗舰店




一、试验原理:
弧菌显色培养基是青岛海博生物公司改良的培养基,用于食品、海产品、病人粪便样品和水产品中副溶血性弧菌的快速检测。副溶血性弧菌显蓝绿色且菌落比较大,霍乱弧菌和创伤弧菌显紫红色,溶藻弧菌显淡黄色或米黄色,其它细菌绝大部分被抑制。本培养基的特异性高,可以克服TCBS培养基引起的假阴性结果,是一种很理想的快速检测培养基。
弧菌自身代谢产生的酶与相应显色底物反应使菌落显色,以区分目标菌与非目标菌。显色底物是由产色因子和微生物部分可代谢物质组成,在特异性酶作用下,游离出产色因子使弧菌菌落显示相应的颜色。
二、培养基配方(g/L):
|
特殊营养物质 |
75.0 |
|
混合显色剂 |
4.45 |
|
琼脂 |
15.0 |
|
pH值8.6±0.1(25℃) |
|
三、试验方法:
1. 称取本品18.9g加入200mL蒸馏水,加热溶解并不停搅拌,煮沸3-5次。冷却至45℃-50℃时,倾入无菌平皿。注意:制备好的培养基表面不能太干燥。
2. 10倍梯度稀释法制备目标菌菌悬液,吸取合适梯度的菌悬液涂布接种于待测培养基和参比培养基上。
3. 非目标菌(特异性)定性测试,接种环取一环质控菌株培养液划线接种至待测平板上。
4. 放置于恒温培养箱36℃±1℃需氧培养18h-24h,观察试验结果。
四、试验结果判断:
接种以下质控菌株,放置于36℃±1℃需氧培养18h-24h,试验结果如图1所示。
|
质控菌株 |
菌株编号 |
接种量(CFU) |
参比或计数培养基 |
方法 |
质控结果 |
其他特征 |
|
副溶血性弧菌 |
ATCC 17802 |
20-200 |
3%NaCl TSA |
定量 |
PR≥0.5 |
蓝绿色,菌落比较大 |
|
溶藻弧菌 |
ATCC 17749 |
/ |
/ |
定性 |
/ |
淡黄色或米黄色 |
|
霍乱弧菌 |
非O1群 |
/ |
/ |
定性 |
/ |
紫红色 |
|
创伤弧菌 |
ATCC 27562 |
/ |
/ |
定性 |
/ |
紫红色 |
|
金黄色葡萄球菌 |
ATCC 25923 |
/ |
/ |
半定量 |
G≤1 |
/ |
|
大肠埃希氏菌 |
ATCC 25922 |
/ |
/ |
半定量 |
G≤1 |
/ |
图1 弧菌显色培养基(第二代)微生物质控结果
注:A:副溶血性弧菌;B:溶藻弧菌;C:霍乱弧菌;D:创伤弧菌;E:金黄色葡萄球菌;F:大肠埃希氏菌
相关产品:
注:本文属海博生物原创,未经允许不得转载。



